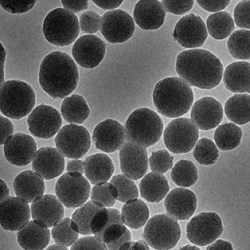
加载中

- 高品质石墨烯
- CVD石墨烯、类石墨烯
- 类石墨烯系列
- 无缺陷单晶石墨烯和类石墨烯(机械剥离)
- 量子点系列
- 聚集诱导发光AIE
- 近红外二区荧光染料
- 石墨炔
- 二维过渡金属碳/氮/硼化物MXene
- 金属威廉希尔手机版 材料和其他生物威廉希尔手机版 材料
- 金属有机框架材料MOF
- 二维层状金属氧化物
- 碳威廉希尔手机版 管
- 碳威廉希尔手机版 管阵列和特殊碳管材料
- 高品质金属、半导体高纯单壁碳管
- 碳威廉希尔手机版 管海绵
- 介孔碳及碳威廉希尔手机版 材料
- 高品质富勒烯
- 一维威廉希尔手机版 材料
- 分子筛
- 无机威廉希尔手机版 材料
- 钙钛矿材料
- 高定向热解石墨HOPG
- 有机材料
- 原子催化剂
- 热电材料
- 储钠专用材料
- 工业级威廉希尔手机版 材料
- 产品解决方案
单层石墨烯粉末
碳化钛(Ti3C2Tx) MXene薄层分散液
20ml 浓度:2.5mg/ml 溶剂:水;50ml {};100ml {};100ml {};5ml {};10ml {};10ml {}
碳化钛(Ti3C2Tx) MXene少层分散液(送滤纸)
20ml 浓度:5mg/ml片径:0.2-5μm溶剂:水;50ml {};100ml {};50ml {};20ml {};20ml {};10ml {};200ml {};500ml {};100ml {};200ml {};500ml {};50ml {};100ml {};50ml {};100ml {};10ml {};20ml {};20ml {};50ml {};20ml {}
多聚赖氨酸修饰的四氧化三铁磁性威廉希尔手机版 颗粒
2.5 mL 尺寸:5nm,Fe浓度:1mg/ml, 溶剂:水;2.5 mL {};2.5 mL {};2.5 mL {};2.5 mL {};2.5 mL {}
高浓度金威廉希尔手机版 颗粒
10ml 直径:8nm,浓度:0.1mg/ml,溶剂:水;10ml {};10ml {};10ml {};10ml {};10ml {};10ml {};5ml {};10ml {};10ml {};10ml {};10ml {};10ml {};10ml {};10ml {};10ml {};10ml {}
氨基实心二氧化硅威廉希尔手机版 颗粒(粉末)
定制 20nm-5um;250mg {};250mg {};250mg {};250mg {};250mg {};250mg {};250mg {};250mg {};250mg {};250mg {};250mg {}
高品质威廉希尔手机版 银颗粒(威廉希尔手机版 银胶体)
10 mL 直径:5nm, C:0.1 mg/mL,溶剂水;10 mL {};10 mL {};10 mL {};10 mL {};10 mL {};10 mL {};10 mL {};10 mL {};10 mL {};10 mL {};10 mL {}
金威廉希尔手机版 颗粒(CTAB修饰)
5ml 直径:5±3nm浓度:0.05mg/ml溶剂:水;10ml {};10ml {};10mL {};10mL {};10mL {};10mL {}
ACS MaterialCVD铜基石墨烯薄膜 3cmx3cm
1 片 单层,3cmx3cm, 铜箔厚度约25微米;1 片 {};1 片 {};1 片 {};1 片 {};1 片 {};1 片 {};1 片 {};1 片 {}
Nanocor有机蒙脱土
100g 有机蒙脱土,备注型号;200g {};500g {};100g {};100g {};100g {};200g {};200g {};200g {}
Nanocor无机蒙脱土(钠基)
100g 纯度大于98%,备注型号;200g {};500g {};100g {};100g {};100g {};200g {};200g {};200g {}
实心二氧化硅威廉希尔手机版 颗粒(粉末)
250mg 平均尺寸:~200nm;250mg {};定制 {};250mg {};250mg {};250mg {};250mg {};250mg {};250mg {}
二氧化钛威廉希尔手机版 颗粒
10mL 直径:150±20nm,浓度1mg/ml,溶剂乙醇;定制 {};10mL {};10mL {};10mL {};10mL {};10mL {};10mL {};10mL {}
PEI修饰金威廉希尔手机版 颗粒
10 mL 直径:10nm浓度:0.05mg/ml溶剂:水;10 mL {};10 mL {};10 mL {};10 mL {};10 mL {};10 mL {};10 mL {};10 mL {};10 mL {}
羧基化聚苯乙烯微球
10mL 粒径:20nm 固含量:2.5%;10mL {};10mL {};定制 {};10mL {};10ml {};10ml {};10mL {};10mL {};10mL {};10mL {};10mL {};10mL {};10 mL {};10 mL {};10 mL {};10 mL {};10 mL {}
绿色荧光单分散聚苯乙烯微球
1mL 尺寸: 100nm,溶剂:水,固含量:1%;1mL {};1mL {};1mL {};1mL {};定制 {};1mL {};1mL {};1mL {};1mL {};1mL {};1mL {};1mL {};1mL {}
巯基修饰的四氧化三铁磁性威廉希尔手机版 颗粒(高温热解法)
2.5 mL 尺寸:~10nm Fe浓度:1mg/ml溶剂:水;5 mL {};10 mL {};2.5 mL {};2.5 mL {};2.5 mL {}
单分散聚苯乙烯红色荧光微球
1mL 浓度:10 mg/mL,尺寸:200±10 nm,溶剂:水;1mL {};定制 {};1mL {};1mL {};1mL {};1mL {};1mL {};1mL {};1mL {};1mL {};1mL {}
羧基实心二氧化硅威廉希尔手机版 颗粒
10mL 平均尺寸:~20nm;10mL {};10mL {};10mL {};10mL {};10mL {};10mL {};10mL {};10mL {};10mL {};10mL {};10mL {};10mL {};10mL {};10mL {}
单分散聚苯乙烯微球
10 mL 粒径:~240 nm;10ml {};10ml {};10ml {};10ml {};10ml {};10ml {};10ml {};10ml {};10ml {};10ml {}
实心二氧化硅威廉希尔手机版 颗粒
10mL 平均尺寸:~200nm;10mL {};10mL {};10mL {};10mL {};10mL {};10mL {};10mL {};10mL {};10mL {};10mL {};10mL {};10mL {};10mL {};10mL {};10mL {};10mL {};10mL {}
碳化钛(Ti3C2Tx) MXene少层分散液
20ml 浓度:5mg/ml 溶剂:NMP;50ml {};100ml {};20ml {};50ml {};100ml {};50ml {};50ml {};100ml {};100ml {}
羧基化四氧化三铁磁性威廉希尔手机版 颗粒(高温热解法)
10mg D:~10nm,Fe:~4mg/mL,溶剂:水;20mg {};40mg {};10mg {};20mg {};40mg {};10mg {};20mg {};40mg {};10mg {};20mg {};40mg {};10mg {};20mg {};40mg {}
单层石墨烯分散液(XFZ20分散)
20 ml 浓度:0.5mg/ml 溶剂:水;100 ml {};200ml {};50 ml {};20ml {};50ml {};100ml {};200ml {};20ml {};50ml {};100ml {};200ml {};500ml {};500ml {};500ml {};20ml {};50ml {};100ml {};200ml {};50ml {};20ml {};20ml {}
羧基中空介孔二氧化硅(球状)
50mg 平均直径:~200 nm;100mg {};50mg {};100mg {};50mg {};100mg {};50mg {};100mg {}
氨基中空介孔二氧化硅(球状)
50mg 平均直径:~200 nm;100mg {};50mg {};100mg {};50mg {};100mg {};50mg {};100mg {};50mg {}
中空介孔二氧化硅(球状)
50mg 直径:~200 nm;100mg {};50mg {};100mg {};50mg {};100mg {};50mg {};100mg {};200mg {};50mg {};100mg {};200mg {};50mg {};100mg {}
锂插层钼钨硫MoWS2威廉希尔手机版 片分散液
200ml 浓度:1mg/ml,溶剂水;500ml {};200ml {};500ml {};200ml {};500ml {};100ml {}
油溶性银威廉希尔手机版 颗粒
10ml D:20nm,C:0.1mg/ml;10ml {};10ml {};10ml {};10ml {};10ml {};10ml {};10ml {};10ml {};10mL {};10mL {}
纯四氧化三铁威廉希尔手机版 颗粒
10mg 浓度:1mg/ml,直径:50nm,溶剂:水;10mg {};10mg {};10mg {};10mg {};10mg {};10mg {};10mg {};10mg {};10mg {};25mg {}
氧化石墨烯分散液(1-6层)
20 mL 浓度:5 mg/ml ,溶剂:水;50 mL {};100mL {};200mL {};20mL {};50mL {};100mL {};200mL {};500mL {};500mL {};200mL {}
定制二维威廉希尔手机版 材料分散液
50ml 定制黑磷威廉希尔手机版 片,浓度0.2mg/ml溶剂水(深度加工片径:50-200nm);50ml {};50ml {};50ml {};50ml {};50mL {};10ml {};50ml {}
氧化石墨烯分散液 1-5层
100 mL 浓度:0.5 mg/ml 厚度:1-5层 溶剂:水;200 ml {};500 ml {};1 L {};100 ml {};200 ml {};500 ml {};1 L {};100 ml {};200 ml {};500 ml {};1 L {}
代购服务
代购 代购;50g {};500 mg {};5g {};25片 {};10片 {};500mg {};1片 {};50g {};100ml {};100ml {};1kg {}
定制CVD石墨烯膜
定制 承接定制;定制 {};定制 {};1片 {};1片 {};1片 {};1片 {};1片 {};1片 {};1片 {};1片 {};1片 {};1片 {};1片 {};1片 {};1片 {};1片 {};1片 {};1片 {};1片 {};1片 {};1片 {};1片 {};1片 {};1片 {};1片 {};1片 {};1片 {};1片 {};1片 {};1片 {};1片 {};1片 {};1片 {};1片 {};1片 {};1片 {};1片 {};1片 {};1片 {};1片 {};1片 {};1片 {};1片 {};1片 {};1片 {};1片 {};1片 {};1片 {};1片 {};1片 {};1片 {};1片 {};1片 {};1片 {};1片 {};1片 {};1片 {};1片 {};1片 {};1片 {};1片 {};1片 {};1片 {};1片 {};1片 {}
单分散聚苯乙烯微球
10 mL 粒径:250nm;定制 {};10 mL {};10 mL {};10 mL {};10 mL {};10 mL {};10 mL {};10 mL {};10 mL {};10 mL {};10mL {};10 mL {};10 mL {};10 mL {};10 mL {};10 mL {};10 mL {};10 mL {};10 mL {};10 mL {};10 mL {};10 mL {};10 mL {};10 mL {};10 mL {};10 mL {};10 mL {};10 mL {};10 mL {};10 mL {};10 mL {}
黑磷量子点分散液
100 mL 浓度:0.1mg/ml 溶剂:乙醇;50 mL {};25ml {};100 ml {};50ml {};50ml {};50ml {};50ml {};100 mL {};100 mL {};100 mL {};50 mL {};50 mL {};50 mL {};20 mL {};50 mL {};50 mL {}
黑磷威廉希尔手机版 片分散液
100 mL 浓度:0.2mg/ml,溶剂:水;200 mL {};50 mL {};50 mL {};50ml {};50ml {};50ml {};50ml {};50ml {};50ml {};100 mL {};100 mL {};100 mL {};200 mL {};200 mL {};200 mL {};50 mL {};50 mL {};50 mL {};50 mL {};50 mL {};50 mL {};50ml {};10ml {};10ml {};10ml {}
银威廉希尔手机版 线 30nm
500 mg C:10 mg/mL 长度:约20um 溶剂:水;500 mg {};500 mg {};1 g {};1 g {};1 g {};250 mg {};250 mg {};250 mg {};250 mg {};250 mg {};250 mg {}
超大长径比银威廉希尔手机版 线L70
500mg 直径:70nm 浓度:20mg/ml 溶剂:水 ;500mg {};500mg {};1g {};1g {};1g {};500mg {};500mg {};500mg {}
超大长径比银威廉希尔手机版 线L30
500mg 直径:30威廉希尔手机版 浓度:20mg/ml 溶剂:水;500mg {};500mg {};1g {};1g {};1g {};500mg {};500mg {};500mg {}
NanoIntegris半导体性单壁碳管99.9%固体
1 mg 直径: 1.2-1.4 nm,长度: ~2 µm;5 mg {};10 mg {};15 mg {};20 mg {}
NanoIntegris 金属性单壁碳威廉希尔手机版 管99%片状固体
1 mg 直径: 1.2-1.7 nm,长度: 300 nm-5 μm;5 mg {};10 mg {};30 mg {}
NanoIntegris金属性单壁碳威廉希尔手机版 管98%片状固体
1 mg 直径: 1.2-1.7 nm,长度: 300 nm-5 μm;5 mg {};10 mg {};30 mg {};150 mg {}
NanoIntegris 金属性单壁碳威廉希尔手机版 管95%片状固体
1 mg 直径: 1.2-1.7 nm,长度: 300 nm-5 μm;5 mg {};10 mg {};30 mg {};150 mg {}
NanoIntegris 金属性单壁碳威廉希尔手机版 管90%片状固体
1 mg 直径: 1.2-1.7 nm,长度: 300 nm-5 μm;5 mg {};10 mg {};30 mg {};150 mg {}
NanoIntegris金属性单壁碳威廉希尔手机版 管70%片状固体
1 mg 直径: 1.2-1.7 nm,长度: 300 nm-5 μm;5 mg {};10 mg {};30 mg {};150 mg {}
NanoIntegris半导体性单壁碳威廉希尔手机版 管99%片状固体
1 mg 直径: 1.2-1.7 nm,长度: 300 nm-5μm;5 mg {};10 mg {};30 mg {};150 mg {}
NanoIntegris半导体性单壁碳威廉希尔手机版 管98%片状固体
1 mg 直径: 1.2-1.7 nm,长度: 300 nm-5 μm;5 mg {};10 mg {};30 mg {};150 mg {}
NanoIntegris 半导体性单壁碳威廉希尔手机版 管95%片状固体
1 mg 直径: 1.2-1.7 nm,长度: 300 nm-5 μm;5 mg {};10 mg {};30 mg {}
NanoIntegris半导体性单壁碳威廉希尔手机版 管90%片状固体
1 mg 直径: 1.2-1.7 nm,长度: 300 nm-5 μm;5 mg {};10 mg {};30 mg {}
NanoIntegris 半导体性单壁碳威廉希尔手机版 管99.9%溶液
1 mg 直径: 1.2-1.4 nm,长度:~ 2μm;5 mg {};10 mg {};15 mg {};20 mg {}
转移碳威廉希尔手机版 管垂直阵列 玻璃基底
1cm x 1cm 方形, 纯度: 95%, 单面,厚度可定制;2cm x 2cm {};1cm x 1cm {};2cm x 2cm {}
转移碳威廉希尔手机版 管垂直阵列 塑料基底
1cm x 1cm 方形, 纯度: 95%, 单面,厚度可定制;2cm x 2cm {};1cm x 1cm {};2cm x 2cm {}
高品质超大长径比银威廉希尔手机版 线直径L100
500 mg 直径:100nm 浓度:20mg/ml 溶剂:水;500 mg {};500 mg {};1 g {};1 g {};1 g {};500 mg {};500 mg {};500 mg {}
转移碳威廉希尔手机版 管垂直阵列 金属基底
1cm x 1cm 方形, 纯度: 95%, 单面,厚度可定制;2cm x 2cm {};1cm x 1cm {};2cm x 2cm {}
高导电碳威廉希尔手机版 管膜
1 片 圆形, 直径:2cm;1 片 {};1 片 {};1 片 {};1 片 {};1 片 {};1 片 {};定制尺寸 {};1 片 {};1 片 {};1 片 {};1 片 {};1 片 {};1 片 {};1 片 {};1 片 {};1 片 {}
PEG化四氧化三铁威廉希尔手机版 颗粒(氨基末端)
2.5 mL 尺寸:~10nm Fe浓度:1mg/ml溶剂:水;5 mL {};10 mL {};定制 {};2.5 mL {};2.5 mL {};2.5 mL {};2.5 mL {};2.5 mL {};2.5 mL {}
PEG化四氧化三铁威廉希尔手机版 颗粒(羧基末端)
2.5 mL 尺寸: ~10 nm Fe浓度:1mg/ml 溶剂:水;5 mL {};10 mL {};定制 {};2.5 mL {};5 mL {};10 mL {};2.5 mL {};5 mL {};2mL {};2.5 mL {};2.5 mL {};2.5 mL {}
PEG化四氧化三铁威廉希尔手机版 颗粒(甲氧基末端)
2.5 mL 尺寸: ~10 nm Fe浓度:1mg/ml 溶剂:水;5 mL {};10 mL {};定制 {};2.5 mL {}
聚乙烯亚胺PEI修饰的磁性四氧化三铁威廉希尔手机版 颗粒
2.5 ml 尺寸:~10nm Fe浓度:1mg/ml 溶剂:水;5 ml {};10 ml {};2.5 ml {};5 ml {};10 ml {};2.5 ml {};5 ml {};10 ml {};2.5 ml {};5 ml {};10 ml {};2.5 ml {};5 ml {};10 ml {};2.5 mL {};5 mL {};10 mL {};2.5 mL {}
羧基化四氧化三铁威廉希尔手机版 颗粒(共沉淀法)
10 mg D:~7nm,Fe:~4mg/mL,溶剂:水;20 mg {};40 mg {};10 mg {};20 mg {};40 mg {};10mg {};20 mg {};40 mg {};10mg {};20 mg {};40 mg {}
油酸修饰的四氧化三铁磁性威廉希尔手机版 颗粒(高温热解法)
2.5 ml 尺寸: ~10nm 溶剂:氯仿 Fe:1mg/ml;5 ml {};50 mg {};100 mg {};2.5 ml {};5 ml {};2.5 ml {};5 ml {};2.5 ml {};5 ml {};2.5 ml {};5 ml {};2.5 ml {};5 ml {};2.5 ml {};5 ml {};2.5 ml {};5 ml {};2.5 ml {};5 ml {};2.5 ml {};5 ml {};50 mg {};100 mg {};50 mg {};100 mg {};50 mg {};100 mg {};50 mg {};100 mg {}
油酸修饰的四氧化三铁磁性威廉希尔手机版 颗粒(共沉淀法)
2.5 ml 尺寸小于10 nmFe浓度1mg/ml 溶剂氯仿;5 ml {};10 ml {};100 mg {};2ml {};2.5 ml {};5 ml {};10 ml {};2.5 ml {};5 ml {};10 ml {};2.5 ml {};5 ml {};2.5 ml {};10 ml {};5 ml {};10 ml {};100 mg {};100 mg {};100 mg {};100 mg {};2.5 mL {}
银威廉希尔手机版 颗粒(威廉希尔手机版 银胶体)
10 mL 直径:20 nm, C:0.1 mg/mL,溶剂水;10 mL {};10 mL {};10 mL {};10 mL {};10 mL {};10 mL {};10 mL {};10 mL {};10 mL {};10 mL {};10 mL {};10 mL {};10 mL {};10 mL {};10 mL {};10 mL {};10 mL {};5mL {};5mL {}
金威廉希尔手机版 棒(CTAB修饰)
10 mL 长径比2.0 吸收峰:约610nm溶剂水;10 mL {};10 mL {};10 mL {};10 mL {};10 mL {};10 mL {};10 mL {};10 mL {};10 mL {};10 mL {};10 mL {};10 mL {};10 mL {};10 mL {};10 mL {};10 mL {};10 mL {};10 mL {};10 mL {};10 mL {};10 mL {};10 mL {};10 mL {};10 mL {};10 mL {};10 mL {};10 mL {};10 mL {};10 mL {};10 mL {}
金威廉希尔手机版 颗粒(威廉希尔手机版 金胶体)
10 mL 直径:20nm浓度:0.05mg/ml,溶剂:水;10 mL {};10 mL {};10 mL {};10 mL {};10 mL {};10 mL {};10 mL {};10 mL {};10 mL {};10 mL {};10 mL {};10 mL {};10 mL {};10 mL {};10 mL {};10 mL {};10 mL {};10 mL {};10 mL {}
薄层二硫化钼分散液
200 ml 浓度:1mg/ml溶剂:水 稳定剂:LiOH;500 ml {};200 ml {};500 ml {};100ml {};100 ml {};40ml {};40ml {};200ml {};500 ml {};200ml {};500 ml {}
小片径少层二硫化钨分散液 浓度0.1mg/mL(送原液)
200 ml 浓度: 0.1mg/ml,溶剂: 水;500 ml {};200 ml {};500 ml {};200 ml {};500 ml {}
少层二硫化钨分散液 浓度0.1 mg/mL (送原液)
200 ml 浓度: 0.1mg/ml, 溶剂: 水;500 ml {};200 ml {};500 ml {};200 ml {};500 ml {}
少层二硫化钨分散液
200 ml 浓度: 1mg/ml, 溶剂: 水,稳定剂:LiOH;500 ml {};200 ml {};500 ml {};200 ml {};200 ml {};100 ml {}
小片径薄层二硫化钨分散液
200 ml 浓度:1mg/ml, 溶剂:水,稳定剂:LiOH;500 ml {};200 ml {};500 ml {};200 ml {};100 ml {}
薄层二硫化钨分散液 浓度1 mg/mL
200 ml 浓度:1mg/ml溶剂:水,稳定剂:LiOH;500 ml {};200 ml {};500 ml {};200 ml {};40ml {}
少层二硫化钼分散液
200 ml 浓度:1mg/ml,溶剂:水,稳定剂:LiOH;500 ml {};200 ml {};500 ml {};200 ml {};500 ml {};100 ml {};200 ml {}
小片径薄层二硫化钼分散液 浓度1 mg/mL
200 ml 浓度:1mg/ml,溶剂:水,稳定剂:LiOH;500 ml {};200 ml {};500 ml {};100 ml {}
石墨烯量子点 发绿光
100 ml 浓度: 1mg/ml 溶剂:水和少量DMF;50 ml {};100 ml {};50ml {};50ml {};10ml {};10ml {};10ml {}
定制碳威廉希尔手机版 管分散液
定制 0;500ml {};500ml {};200ml {};500ml {};100ml {};100ml {};500ml {};500ml {};100ml {};500ml {};100ml {};500ml {};1L {};1L {};500ml {};200ml {};100ml {};300ml {};100g {};100g {};500ml {};500ml {};500ml {};1kg {};100ml {};100g {};500ml {};400ml {};200ml {};400ml {};400ml {};400ml {};400ml {};400ml {};200ml {};500ml {};200ml {};1L {};500ml {};900ml {};1L {};500ml {};400ml {};400ml {};1L {};1L {};200ml {};200ml {};200ml {};200ml {};100ml {};100g {};180ml {};1kg {};20ml {};200mL {};1L {};1L {};1L {};1L {};500mL {};480ml {};500g {};50ml {};400ml {};1000ml {};200ml {};100ml {};100ml {};500ml {};500ml {};500ml {};500ml {};500ml {};500ml {};100g {};500ml {};100g {};100ml {}
单层氧化石墨烯分散液 片径50-200nm
20 ml 浓度:0.5mg/ml 溶剂: 水;50 ml {};100 ml {};200 ml {};500 ml {};1000 ml {};20 ml {};50 ml {};100 ml {};200ml {};500 ml {};1000 ml {};20 ml {};50 ml {};100 ml {};200 ml {};500 ml {};1000 mL {};50 ml {};50 ml {};200 ml {};100ml {};500ml {};20 ml {};100ml {};50 ml {};20ml {};20ml {};100ml {};20ml {};50ml {};100ml {};100ml {};100ml {};1000 ml {};250ml {};20ml {}
ZSM-5
100 g 硅铝比:38,孔径:0.53~0.58 nm,;500 g {};100 g {};500 g {};100 g {};500 g {};100 g {};500 g {};100 g {};500 g {}
石墨相氮化碳 g-C3N4
500 mg 尺寸:0.1-10μm, 纯度99%;1 g {};5 g {};10g {};30g {};50g {};100g {};500g {};1kg {}
Nanointegris超纯单壁碳威廉希尔手机版 管溶液
25 mg OD: 1.2 nm-1.7 nm,Purity: 99%;100 mg {};250 mg {};500 mg {};1 g {}
NanoIntegris 金属性单壁碳威廉希尔手机版 管98%溶液
1 mg 直径: 1.2-1.7 nm,长度: 300 nm-5 μm;5 mg {};10 mg {};30 mg {};150 mg {}
NanoIntegris 金属性单壁碳威廉希尔手机版 管95%溶液
1 mg 直径: 1.2-1.7 nm,长度: 300 nm-5 μm;5 mg {};10 mg {};30 mg {};150 mg {}
NanoIntegris金属性单壁碳威廉希尔手机版 管90%溶液
1 mg 直径: 1.2-1.7 nm,长度: 300 nm-5 μm;5 mg {};10 mg {};30 mg {};150 mg {}
NanoIntegris 金属性单壁碳威廉希尔手机版 管70%溶液
1 mg 直径: 1.2-1.7 nm,长度: 300 nm-5 μm;5 mg {};10 mg {};30 mg {};150 mg {}
NanoIntegris半导体性单壁碳威廉希尔手机版 管99%溶液
1 mg 浓度约0.01mg/ml,溶剂水;5 mg {};10 mg {};30 mg {};150 mg {};3mg {}
NanoIntegris 半导体性单壁碳威廉希尔手机版 管98%溶液
1 mg 直径: 1.2-1.7 nm,长度: 300 nm-5 μm;5 mg {};10 mg {};30 mg {};150 mg {}
NanoIntegris半导体性单壁碳威廉希尔手机版 管95%溶液
1 mg 直径: 1.2-1.7 nm,长度: 300 nm-5 μm;5 mg {};10 mg {};30 mg {};150 mg {}
NanoIntegris 半导体性单壁碳威廉希尔手机版 管90%溶液
1 mg 直径: 1.2-1.7 nm,长度: 300 nm-5 μm;5 mg {};10 mg {};30 mg {}
Nanointegris小管径单壁碳管Raw Fluffy Powder
500 mg D:0.8-1.2 nm,Fe Catalyst 35%;1 g {};5 g {};10 g {}
威廉希尔手机版 银胶体
500 ml 直径:15±5nm,浓度:100ppm溶剂:水;1000 ml {};100 ml {};100 ml {};500 ml {};1000 ml {};1000 ml {}
高品质超大长径比银威廉希尔手机版 线 直径L50
1 g 直径:50nm 浓度:20mg/ml 溶剂:水;1 g {};1 g {};500 mg {};500 mg {};500 mg {};500 mg {};500 mg {};500 mg {}
高品质银威廉希尔手机版 线 直径120nm
1g 直径:120nm 浓度:20mg/ml 溶剂:水;1g {};1g {};500 mg {};500 mg {};500 mg {};500 mg {};500 mg {};500 mg {}
高品质银威廉希尔手机版 线 直径90 nm
1 g 直径:90nm 浓度:20mg/ml 溶剂:水;1 g {};1 g {};500 mg {};500 mg {};500 mg {};500 mg {};500 mg {};500 mg {}
高品质银威廉希尔手机版 线 直径60 nm
1 g 直径:60nm 浓度:20mg/ml 溶剂:水;1 g {};1 g {};500 mg {};500 mg {};500 mg {};500 mg {};500 mg {};500 mg {}
高品质银威廉希尔手机版 线 直径50 nm
1 g 直径:50nm 浓度:20mg/ml 溶剂:水;1 g {};1 g {};500 mg {};500 mg {};500 mg {};500 mg {};500 mg {};500 mg {}
高品质银威廉希尔手机版 线 直径200 nm
1 g 直径200威廉希尔手机版 长度25微米 溶剂水;1 g {};1 g {};500 mg {};500 mg {};500 mg {}
高品质银威廉希尔手机版 线 直径40 nm
1 g 直径:40nm浓度:20mg/ml溶剂:水;1 g {};1 g {};500 mg {};500 mg {};500 mg {};500 mg {};500 mg {};500 mg {}
ACS Material CVD铜基石墨烯薄膜 10cmx10cm
1 盒 单层,10cmx10cm, 铜箔厚度约25微米;1 盒 {};1 盒 {};1 盒 {};1 盒 {};1 盒 {};1 盒 {};1 盒 {};1 盒 {}
ACS MaterialCVD铜基石墨烯薄膜 1cmx1cm
1 盒 单层,1cmx1cm, 铜箔厚度约25微米;1 盒 {};1 盒 {};1 盒 {};1 盒 {};1 盒 {};1 盒 {};1 盒 {};1 盒 {};1 盒 {}
ACS Material CVD铜基石墨烯薄膜 2cmx2cm
1 盒 单层,2cmx2cm, 铜箔厚度约25微米;1 盒 {};1 盒 {};1 盒 {};1 盒 {};1 盒 {};1 盒 {};1 盒 {};1 盒 {}
ACS Material CVD铜基石墨烯薄膜 5cmx5cm
1 盒 单层,5cmx5cm, 铜箔厚度约25微米;1 盒 {};1 盒 {};1盒 {};1 盒 {};1 盒 {};1 盒 {};1 盒 {}
ACS Material CVD铜基石墨烯薄膜 10cmx5cm
1 盒 单层,10cmx5cm, 铜箔厚度约25微米;1 盒 {};1 盒 {};1 盒 {};1 盒 {};1 盒 {};1 盒 {};1 盒 {}
单层氧化石墨烯分散液 片径小于500 nm
20 ml 浓度:0.5mg/ml 溶剂:水;50 ml {};100 ml {};500 ml {};1000 ml {};20 ml {};50 ml {};100 ml {};500 ml {};1000 ml {};20 ml {};50 ml {};100 ml {};500 ml {};1000 ml {};200 ml {};200 ml {};200 ml {};100 ml {};100 ml {};50 ml {};50ml {};20ml {};50ml {};500 ml {}
单层氧化石墨烯分散液 片径大于500 nm
20 ml 浓度:0.5mg/ml 溶剂: 水;50 ml {};100 ml {};200 ml {};500 ml {};1000 ml {};20 ml {};50 ml {};100 ml {};200ml {};500 ml {};1000 ml {};20 ml {};50 ml {};100 ml {};200 ml {};500 ml {};1000 ml {};20 ml {};50 ml {};100 ml {};200 ml {};500 ml {};1000 ml {};20 ml {};50 ml {};100 ml {};200 ml {};500 ml {};1000 ml {};20 ml {};50 ml {};100 ml {};200 ml {};500 ml {};1000 ml {};20 ml {};50 ml {};100 ml {};200 ml {};500 ml {};1000 ml {};20 ml {};50 ml {};100 ml {};200 ml {};500 ml {};1000 ml {};20 ml {};50 ml {};100 ml {};200 ml {};500 ml {};1000 ml {};10ml {};500 ml {};20ml {};250ml {};20ml {};100 ml {};100 ml {};100 ml {};1000 ml {};100ml {};20 ml {};50 ml {}
单层石墨烯分散液(PVP分散)
20 ml 浓度:0.5mg/ml 溶剂:水;100 ml {};200 ml {};500 ml {};1000 ml {};20 ml {};100 ml {};200 ml {};500 ml {};1000 ml {};20 ml {};100 ml {};200 ml {};500 ml {};1000 ml {};20 ml {};100 ml {};200 ml {};500 ml {};1000 ml {};50 ml {};50 ml {};50 ml {};50 ml {};10ml {};50 ml {};100ml {};20ml {};100 ml {};20 ml {};1000 ml {};100ml {}